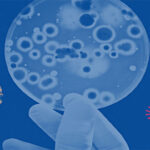

ඊයේ (03) පාකිස්තානයේ සියල්කොට් නගරයේ දී අමානුෂික ලෙස ශ්රී ලාංකිකයෙකු ඝාතනය කිරීමේ සිද්ධිය මේවන විට ජාත්යන්තර මාධ්යවල ද ආන්දෝලනාත්මක සිද්ධියක් ලෙස වාර්තා කර තිබෙනවා. මෙලෙස ඝාතනයට ලක් වූයේ ප්රියන්ත කුමාර දියවඩන නමැති කළමනාකාරවරයෙක්. මේ අතර මෙම ඝාතනය පිටුපස ඇත්...

ආණ්ඩු පක්ෂයේ මන්ත්රීවරු 38 දෙනෙකුගේ අත්සනින් යුක්තව කථානායකවරයාට ලිපියක් යොමුකර තිබෙනවා. ඒ පාර්ලිමේන්තු මන්ත්රී මනූෂ නානායක්කාර මහතාට එරෙහිව අපක්ෂපාතී පරීක්ෂණයක් සිදුකොට ගත හැකි උපරිම විනය ක්රියාමාර්ග ගන්නා ලෙස ඉල්ලමින් ය. මනූෂ නානායක්කාර සිය ආසනයෙන් නැගිට ප්...

පුපුරන ද්රව්ය තොගයක් රැගෙන කටුනායක බණ්ඩාරනායක ගුවන් තොටුපොළ පරිශ්රයට ඇතුල් වීමට උත්සහ දැරූ පුද්ගලයෙකු අත්අඩංගුවට ගෙන තිබෙනවා. ගුවන් තොටුපොළ පොලීසිය පවසන්නේ මෙම පුද්ගලයා වෑන් රථයක පුපුරන ද්රව්ය පටවාගෙන ගුවන් තොටුපොළ භූමියට ඇතුලු වීමට උත්සහ දරා ඇති බව යි. ...

යුද හමුදාපති ශවේන්ද්ර සිල්වා මහතාට ජනපතිවරයා තවත් වගකීමක් භාර දී තිබෙනවා. දැනට උසුලන කොවිඩ් මර්දන බළකායේ ප්රධානී ධුරයට අමතරව යුද හමුදාපතිවරයාට අලුතින් පිහිටුවීමට නියමිත හරිත කෘෂිකර්ම ක්රියාන්විත මධ්යස්ථානයේ මූලිකත්වයද භාර දීමටයි ජනපතිවරයා තීරණය කර තිබෙන්නේ. ...
මෙරටදී ඔමික්රෝන් ආසාදිතව හඳුනාගෙන ඇති රෝගියා මෙරටට පැමිණි සංචාරකයෙක් නොව දකුණු අප්රිකාවේ සිට මෙරටට පැමිණි ශ්රී ලාංකිකයකු බවට හඳුනාගෙන ඇතැයි ද, මෙරටට පැමිණීමට තහනම් කර ඇති රටවල් 06 න් පසුගිය දින 21 ක කාලයේ දී මෙරටට කිසිදු සංචාරකයකු පැමිණ නැතැයි ද සංචාරක ඇමැත...

කාර්මික කටයුතු සහ ආදාහනාගාර කටයුතු සඳහා ගෑස් නිකුත් කිරීමට අදාළ සමාගම් දෙකට අවසර දී තිබේ. ඒ අනුව ලිට්රො හා ලාෆ්ස් සමාගම් දෙකට පාරිභෝගික කටයුතු අධිකාරිය එලෙස අවසර දී ඇත. ගෑස් අනතුරු සම්බන්ධයෙන් දිවයිනේ විවිධ ප්රදේශවලින් මතුවූ තත්ත්වයත් සමග මෙම සමාගම් දෙකම ගෘහස්ථ ගෑස් සිලින්ඩර...

නොරොච්චෝලේ බලාගාරය යථා තත්ත්වයට පත්කරන තෙක් දිවයිනේ ප්රදේශ කිහිපයකට අවම වශයෙන් පැයක කාලයක් හෝ විදුලි සැපයීම අත්හිටුවීමට සිදුවිය හැකි බව විදුලිබල අමාත්යාංශය පවසයි. නිවේදනයක් නිකුත් කරමින් එම අමාත්යාංශය සඳහන් කළේ පස්වරු 6.00යේ සිට පස්වරු 9.00 දක්වා කාලය තුළ මෙලෙස විදුලි...

ශ්රීරී ලංකා පොදුජන පෙරමුණ නියෝජනය කරන පාර්ලිමේන්තු මන්ත්රීවරුන් පමණක් අද (04) දිනයේ අගමැති මහින්ද රාජපක්ෂ මහතා සමග විශේෂ සාකච්ජාවක් පැවැත්වීමට සැලසුම් කර ඇත. අද සවස 6 ට අරලිය ගහ මන්දිරයේදී මෙම රැස්වීම පැවැත්වීමට නියමිතව තිබේ. මේ ආකාරයට පොදු ජන පෙරමුණ පමණක් නියෝජනය කරන මන්ත්&...

පකිස්ථානයේ සියල්කොට් නගරයේ වසිරාබාද් පාරේදී මහදහවල් ඝාතනය කර පුළුස්සා දැමූ ප්රියන්ත කුමාර නමැති ශ්රී ලාංකික ඉන්ජිනේරුවාගේ ඝාතනයට සැක පිට ෆර්හාන් ඉඩ්රීස් නම් පාකිස්ථානු ජාතිකයා අත් අඩංගුවට ගත් බව එරට මාධ්යය වාර්තා කර සිටී. මේ වන විට සිද්ධිය සම්බන්ධයෙන් සියයකට වැඩ...

සෞඛ්ය අමාත්යාංශයේ මාධ්ය ප්රකාශක නියෝජ්ය සෞඛ්ය සේවා අධ්යක්ෂ ජනරාල් විශේෂඥ වෛද්ය හේමන්ත හේරත් මහතා මාධ්යය වෙත අදහස් දක්වමින් පවසා සිටියේ මෙතෙක් කොරෝනා ආසාදිත ව මෙරටදී මිය ගිය පුද්ගලයින්ගෙන් 69%ක් කොරෝනා මර්ධන එන්නත් මාත්...

පාකිස්ථානයේ එක්ස්ප්රස් ට්රිබියුන් වෙබ් අඩවිය ඊයේ(03) වාර්තා කර සිටියේ පකිස්ථානයේ සියල්කෝට් නගරයේදී කර්මාන්ත ශාලාවක සේවකයින් පිරිසක් එහි කළමනාකරුවකු ලෙස සේවය කළ ශ්රී ලාංකිකයකුට පහර දී ඝාතනය කර පුළුස්සා මරා දමා ඇති බවයි. මේ අතර සියල්කොට් දිස්ත්රික් පොලිස් නිලධාරි ...

කොවිඩ් එන්නත් ලබා ගැනීම අනිවාර්ය කිරීම පවතින නීතියට අනුව කළ හැකි බවට උපදෙස් ලබා දීම හරහා නීතිපතිවරයා සිදුකර තිබෙන්නේ මනුෂ්ය ඝාතනය සඳහා අනුබල දීමක් බව නීතිඥ අරුණ ලක්සිරි උණවටුන මහතා පවසනවා. ඔහු මේ බව සඳහන් කරමින් නීතිපතිවරයාගේ තීරණයට එරෙහිව පොලිස් මූලස්ථානය වෙත පැමිණිල්ලක් සිදුකර තිබෙනවා. ...

නාවික හමුදාව විසින් බලහත්කාරයෙන් අත්පත් කර ගැනීමට වෑයම් කරන පෞද්ගලික ඉඩම් සම්බන්ධයෙන් විසඳීමක් ලබාදීමට උතුරු පළාත් ආණ්ඩුකාරයා අසමත් වූ බවට චෝදනා එල්ල වී තිබේ. යාපනය මාදගල් නැගෙනහිර සහ බටහිර ප්රදේශයේ ඔප්පු සතු ඉඩම් හිමියන් සමඟ ඊයේ පෙරවරුවේ පැවති සාකච්ජාවේදී ස්ථිර විසදුමක් ආණ්ඩුකාර ජී...

චීනය විසින් ශ්රී ලංකාවේ ආරම්භ කිරීමට සැලසුම් කර තිබූ දෙමුහුම් බලශක්ති ව්යාපෘති තුනක් නතර කිරීමට තීරණය කර තිබේ. කොළඹ පිහිටි චීන තානාපති කාර්යාලය ට්විටර් පණිවිඩයක් නිකුත් කරමින් මේ බව සඳහන් කරයි. තුන්වන පාර්ශවයකින් පැමිණිය හැකි ආරක්ෂක හේතු මත එම ව්යාපෘතිය මාලදිවයින් දූ...

ප්රවීණ වේදිකා හා ටෙලි නාට්ය නළු සම්පත් තෙන්නකෝන් අභාවප්රාප්ත වී තිබෙනවා. සම්පත් තෙන්නකෝන් මිය යන විට හැට දෙහැවිරිදි වියේ පසු වුණා. පුංචි තිරයේ මෙන්ම ටෙලි නාට්ය, වේදිකාව තුළ කැපීපෙනෙන චරිත රැසක් නිරූපනය කළ සම්පත් මහතා ප්රවීණ වේදිකා නාට්ය ශිල්පි...

මෙරට නිෂ්පාදනය කරන සහ මෙරට ආනයනය කරනු ලබන සියලුම බීජ වල මිල නියාමනය කිරීමට කටයුතු කරන ලෙස කෘෂිකර්ම අමාත්ය මහින්දානන්ද අළුත්ගමගේ මහතා ජාතික බීජ සභාවට උපදෙස් ලබාදී තිබේ. ආනයනික බීජ අලෙවි කරන වෙළෙදුන් ඇතැම් බීජ ග්රෑම් 50ක් රුපියල් 5000ත් 6000ත් අතර මුදලකට අලෙවිකර ගොවියන් සූරාකන බව...

ශ්රී ලංකා ආයෝජන මණ්ඩලයේ අධ්යක්ෂ මණ්ඩලය සහ අධ්යක්ෂ ජනරාල් සිය ධුරවලින් ඉල්ලා අස්වි ඇත. ආයෝජන මණ්ඩලයේ සභාපති වරයාගේ ක්රියාකලාපය සම්බන්ධයෙන් විරෝධය පළ කරමින් ඔවුන් මෙසේ ඉල්ලා අස්විඇති අතර ඉල්ලා අස්වීමේ ලිපි ජනාධිපති ලේකම් කාර්යාලය වෙත (02) යවා ඇතැයිද වාර්තා වේ . ...

ඉන්දියාවේ කර්නාටක ප්රාන්තයෙන් අද කොවිඩ් 19 වෛරසයේ නව ප්රභේදය වන ඔමික්රෝන් ප්රභේදය ආසාදිත රෝගීන් දෙදෙනෙක් හමුවූ බව ප්රාන්ත සෞඛ්ය අමාත්යංශය පවසයි.මෙම ආසාදිතයින් දෙදෙනා වයස 66ත් 46ත් වන පිරිමි පුද්ගලයින්ය. මෙ...

ආයතනවල ලාභය තරකර ගැනීම වෙනුවෙන් මිනී මරන්න සූදානම් වෙන්න එපා! ඒ ලාභය වෙන්වෙන් මේ රටේ අහිංසක අම්මලාගේ දරුවන්ගේ කාන්තාවන්ගේ ජීවිත බිල්ලට ගන්න සූදානම් වෙන්න එපා යැයි ලක්මව දියණියෝ කාන්තා සංගමයේ ජාතික සංවිධායික ප්රියංගා කොතලාවල මහත්මිය අද මාධ්ය අමතමින් පැවසීය. එහිදී වැඩිදුරටත්...

ලිට්රෝ සමාගම නැවත දැනුම් දෙන තුරු ගෑස් බෙදාහැරීම සහ අලෙවිය අත්හිටුවීමට තීරණය කර ඇති බව වාර්තාවේ. ගෑස් ප්රමිතිය සම්බන්ධයෙන් පැහැදිලි සහතිකයක් ලැබෙනතුරු මෙම තීරණය ක්රියාත්මක බවයි එම සමාගම පවසන්නේ. මේ අතර මේ සම්බන්ධයෙන් අප ලාෆ් ගෑස් සමාගමේ සභාපති ඩබ්ලිව් කේක් වෑගපිටියගෙන් සිදු කළ ...

ඉන්දු - ලංකා ගිවිසුම නීති විරෝධී ගිවිසුමක් බවත්, ඒකීය රට ෆෙඩරල් කිරීම හරහා බෙදීමට කිසිසේත්ම ඉඩදිය නොහැකි බවත් මහා විහාර වංශික ශ්ය...

අනුරාධපුර දිස්ත්රික් පාර්ලිමේන්තු මන්ත්රී ජනප්රිය රංගන ශිල්පී උද්දික ප්රේමරත්න මහතාගේ මෝටර් රථයට කිසියම් ...

රජිව් ගාන්ධි ඝාතනය සම්බන්ධයෙන් වරදකරුවන් වී දඬුවම් ලැබ සිට පසුව නිදහස ලැබූ ශ්රී ලාංකිකයන් 4 දෙනා නැවතත් ශ්රී ලංකාවට එවීමට...

ඉන්දියාවේ තමිල්නාඩු ප්රාන්තය වෙත පැනගොස් සිටින ශ්රී ලාංකික දෙමළ ජනතාව සඳහා පුනරුත්ථාපන කඳවුරු 19ක අලුතින් ඉදිකරන ලද නිවාස...

කොටි ත්රස්තවාදියෙකු වන තිලීපන් නැමැත්තා සැමරීමට නැගෙනහිර පළාතේ සිට උතුරු පළාත දක්වා රථ පෙළපාලියකින් තිලීපන්ගේ පිලිරුවක් රැගෙන යමි...

පාර්ලිමේන්තු මන්ත්රී ගජේන්ද්ර කුමාර් පොන්නම්බලම් මහතාට විරෝධතාකරුවන් පිරිසක් විසින් පහරදී ඇතයි වාර්තාවේ. ත් ...

විශ්රාමික ලුතිතන් ජනරාල් ජගත් ඩයස් මහතාගේ කැඳවුම්කාරිත්වයෙන් "මව්බිම පාවාදෙන ද්රෝහීන්ට කළ යුත්තේ කුමක්ද ?- මහජන විනිශ්චය ...

“ස්වරාජ්ය පාලනය” යන මැයින් 1911 සැප්තැම්බර් 9 වැනි දින “සිංහල බෞද්ධයා” පුවත්පතට අනගාරික ධර්මපාලතුමා ලියූ ලිපියෙන්... "ශිල්ප කර්ම...

මාළිගාකන්ද මහෙස්ත්රාත් අධිකරණය අසලදී අද (17)පස්වරුවේ වෙඩි තැබීමක් සිදුව තිබේ. යතුරුපැදියකින් පැමිණි දෙදෙනෙකු විසින් වෙඩිතැබීම සි...

ජාත්යන්තර මත්ද්රව්ය ජාවාරම්කරුවකු මෙන්ම සංවිධානාත්මක අපරාධ කරුවකු වන නදුන් චින්තක වික්රමරත්න නොහොත් හරක් ...